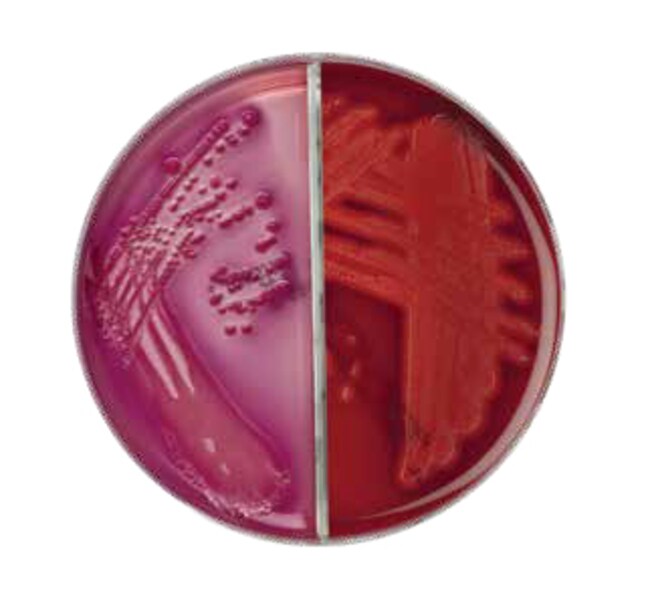

Search
Search
Cultivate, isolate and identify a broad range of microorganisms while simultaneously detecting and enumerating coliform organisms with Thermo Scientific™ Oxoid™ Columbia Agar with Horse Blood/MacConkey Agar without Salt Biplate.
Columbia Blood Agar promotes rapid production of large colonies, clearly defined zones of haemolysis and good colonial differentiation while MacConkey Agar without Salt suppresses the swarming of Proteus species and is, therefore recommended for urine examination in the investigation of suspected urinary tract infection (UTI).
Produce more diagnostic details of pathogenic organisms while reducing storage capacity issue in the incubator with a bi-plate that combines Gram-positive and Gram-negative organism detection on a single plate, allowing laboratories to get the full clinical picture for the next diagnostic decision.
Not all products are available for sale in all territories. Please inquire.
Remel™ and Oxoid™ products are now part of the Thermo Scientific brand